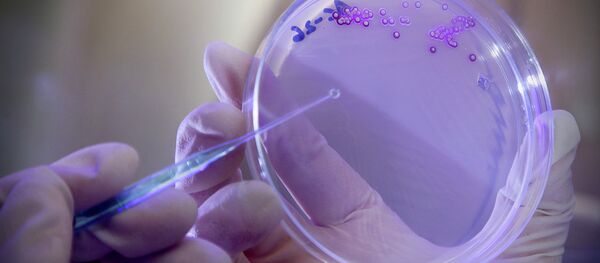

実験でミールワームらは、自然界に戻すことが難しく、大量汚染の原因になっている発泡スチロールをいとも簡単に生分解することがわかった。
研究者らはこの際にミールワームから排出される糞は環境に害を及ぼさず、農作物の肥料として利用できると考えている。
実験でプラスチックを食べ続けたミールワームたちは健康をくずすことはなかった。研究者らは他の虫を使い、ポリプロピレンなど別の種類のプラスチックを分解できないか、解明に努めている。
この研究結果は科学雑誌「エンヴァイロメンタル・サイエンス・テクノロジー」に掲載されている。